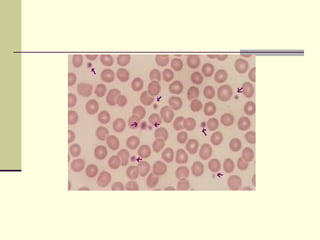
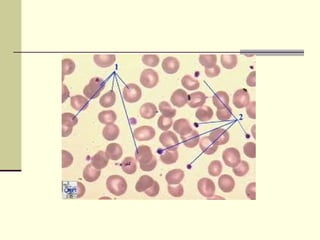

O documento descreve a trombocitopoese, o processo de formação de plaquetas a partir de megacariócitos na medula óssea. As plaquetas são formadas nos estágios III e IV do desenvolvimento do megacariócito através da liberação de pró-plaquetas, que se fragmentam em plaquetas individuais. A trombopoetina controla todos os estágios de desenvolvimento do megacariócito e a quantidade de plaquetas circulantes.